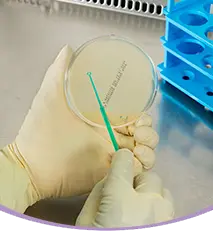
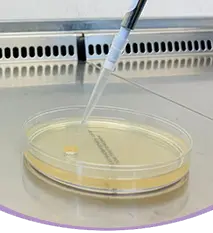

Anti-odor

What Is Staphylococcus hominis & Why We Use It?
How We Test The Anti-odor Property Of Our Products?

Bacterial Plating
The first step involves introducing an inoculum (bacterial component to initiate infection) of Staphylococcus hominis into a culture plate with solidified agar gel containing a sufficientsupply of nutrients like carbs, amino acids, sulfur, nitrogen, and vitamins to aid growth & replication.

Introducing The Test Product & Control
Next, a small well is made in the agar plate containing the bacteria, followed by the addition of the test product. After this, a vancomycin antibiotic disc is placed in a different location on the same plate.It is a small circular piece of filter paper impregnated with the vancomycin antibiotic. Vancomycin inhibits the growth of the multi-drug-resistant Staphylococcus hominis by binding to its surface peptides and preventing cell wall synthesis. This antibiotic disc will serve as a control (reference point) for this well-diffusion experiment. Finally, the bacteria begins to grow under appropriate lab conditions.

Tracking The Zone Of Inhibition

Post the incubation period, clear zones around the vancomycin antibiotic disc and the test product will be formed reflecting no bacterial growth. This area is known as the zone ofinhibition, where bacterial growth is stunted. The diameter of these zones are calculated and compared to interpret the results.
What's The Final Result?
Pick From Our Range Of Tested Anti Odor Products Now
Blog
Product Related Topics









